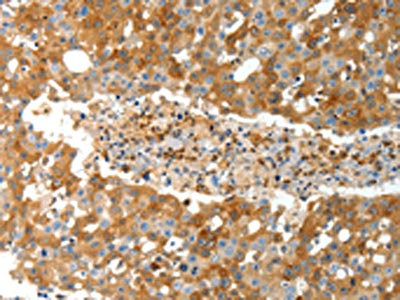

TEP1 Antibody
-
中文名稱:TEP1兔多克隆抗體
-
貨號:CSB-PA275964
-
規(guī)格:¥1100
-
圖片:
-
The image on the left is immunohistochemistry of paraffin-embedded Human breast cancer tissue using CSB-PA275964(TEP1 Antibody) at dilution 1/40, on the right is treated with synthetic peptide. (Original magnification: ×200)
-
The image on the left is immunohistochemistry of paraffin-embedded Human gastric cancer tissue using CSB-PA275964(TEP1 Antibody) at dilution 1/40, on the right is treated with synthetic peptide. (Original magnification: ×200)
-
-
其他:
產(chǎn)品詳情
-
Uniprot No.:
-
基因名:TEP1
-
別名:TEP1 antibody; TLP1 antibody; TP1 antibody; Telomerase protein component 1 antibody; Telomerase-associated protein 1 antibody; Telomerase protein 1 antibody; p240 antibody; p80 telomerase homolog antibody
-
宿主:Rabbit
-
反應(yīng)種屬:Human
-
免疫原:Synthetic peptide of Human TEP1
-
免疫原種屬:Homo sapiens (Human)
-
標(biāo)記方式:Non-conjugated
-
抗體亞型:IgG
-
純化方式:Antigen affinity purification
-
濃度:It differs from different batches. Please contact us to confirm it.
-
保存緩沖液:-20°C, pH7.4 PBS, 0.05% NaN3, 40% Glycerol
-
產(chǎn)品提供形式:Liquid
-
應(yīng)用范圍:ELISA,IHC
-
推薦稀釋比:
Application Recommended Dilution ELISA 1:3000-1:10000 IHC 1:50-1:200 -
Protocols:
-
儲存條件:Upon receipt, store at -20°C or -80°C. Avoid repeated freeze.
-
貨期:Basically, we can dispatch the products out in 1-3 working days after receiving your orders. Delivery time maybe differs from different purchasing way or location, please kindly consult your local distributors for specific delivery time.
-
用途:For Research Use Only. Not for use in diagnostic or therapeutic procedures.
相關(guān)產(chǎn)品
靶點詳情
-
功能:Component of the telomerase ribonucleoprotein complex that is essential for the replication of chromosome termini. Also component of the ribonucleoprotein vaults particle, a multi-subunit structure involved in nucleo-cytoplasmic transport. Responsible for the localizing and stabilizing vault RNA (vRNA) association in the vault ribonucleoprotein particle. Binds to TERC.
-
基因功能參考文獻:
- The current results suggested that genetic variants at TEP1 SNPs rs1760893 and rs1713423 may be associated significantly with increased risk of stomach cancer. PMID: 27305982
- TEP1 Polymorphisms are not associated with Hepatocellular Carcinoma in Thai Patients with Chronic Hepatitis B Virus Infection. PMID: 27221889
- These data suggest that genetic variations in the TEP1 gene may be biomarkers for risk of PCa and BCR after RP. PMID: 26238235
- 8 common SNPs in telomerase reverse transcriptase (TERT) and telomerase-associated protein 1 (TEP1) were genotyped. PMID: 24269974
- the protein levels of MVP, TEP1 and vPARP are actually increased in the highergrade tumors suggesting existence of post-transcriptional regulation of vault component production. PMID: 23739867
- TP1 expression did not change after cisplatin exposure for 72 hours. PMID: 11942411
- TEP1, hTR, hsp90, p23, and dyskerin remained at high and unchanged levels throughout up- or down regulation of telomerase activity. PMID: 12135483
- expression of telomerase activity and its subunit level in pancreatic carcinoma significantly correlate with the clinical stage of pancreatic carcinoma PMID: 12918126
- Telomerase activity and hTERT, TP-1 mRNA expression are up-regulated in esophageal squamous cell carcinoma PMID: 14606063
- The epithelial expression of TP-1 is elevated in mildly active UC. PMID: 18938767
- TEP1, TOPOIIalpha, and HSP90 interact directly with BLM in vitro and modulate its helicase activity on telomere-like DNA substrates but not on non-telomeric substrates. PMID: 19329795
顯示更多
收起更多
-
亞細(xì)胞定位:Nucleus. Chromosome, telomere.
-
組織特異性:Ubiquitous.
-
數(shù)據(jù)庫鏈接:
Most popular with customers
-
YWHAB Recombinant Monoclonal Antibody
Applications: ELISA, WB, IHC, IF, FC
Species Reactivity: Human, Mouse, Rat
-
Phospho-YAP1 (S127) Recombinant Monoclonal Antibody
Applications: ELISA, WB, IHC
Species Reactivity: Human
-
-
-
-
-
-